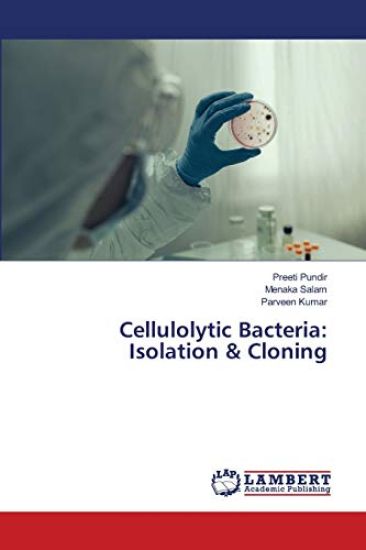
Cellulolytic Bacteria

Automated Lung Cancer Detection System using Image Segmentation
Preeti Joon; Aman Jatain; Shalini Bhashkar · ISBN 9786138390299
Julkaistu 2018 Kieli englanti nidottu
673 tulosta hakusanalla Preetie Boler.

Preeti Joon; Aman Jatain; Shalini Bhashkar · ISBN 9786138390299
Julkaistu 2018 Kieli englanti nidottu

Preeti Pundir; Menaka Salam; Parveen Kumar · ISBN 9786138931560
Julkaistu 2020 Kieli englanti nidottu

Preeti Vaprani; Dayanand Chole; Priyanka Bawa · ISBN 9786138962823
Julkaistu 2021 Kieli englanti nidottu

Preeti Bhagia; Ipseeta Menon; Ricky Pal Singh · ISBN 9786139445943
Julkaistu 2019 Kieli englanti nidottu

Preeti Khandelwal; R. A. Sharma; Mala Agrawal · ISBN 9786139458004
Julkaistu 2019 Kieli englanti nidottu

Preeti Menezes · ISBN 9786139929344
Julkaistu 2018 Kieli englanti nidottu

Preeti Choudhary; Sunil Kumar M. V; Rajesh Kumar · ISBN 9786200308382
Julkaistu 2022 Kieli englanti nidottu

Preeti Sharma; Shubhra Vaish; Nikhil Sharma · ISBN 9786200550880
Julkaistu 2020 Kieli englanti nidottu

Preeti Kale; Raju Anarthe; Amit Mani · ISBN 9786200653789
Julkaistu 2020 Kieli englanti nidottu

Preeti Singh; Nikhil Srivastava; Vivek Rana · ISBN 9786200786661
Julkaistu 2020 Kieli englanti pokkari
All the functional appliances have been designed to treat all types of malocclusion, they are most effective in treating dental and skeletal class II malocclusion, particularly...

Preeti Singh; Amlan Kumar Ghosh · ISBN 9786202003124
Julkaistu 2017 Kieli englanti nidottu

Preeti Naveen Yadav · ISBN 9786202057295
Julkaistu 2022 Kieli englanti nidottu

Preeti Bisht; A. H Ahmad; Alok Mishra · ISBN 9786202519526
Julkaistu 2020 Kieli englanti nidottu

Preeti Singh; Dharmendra Ahuja · ISBN 9786202524568
Julkaistu 2020 Kieli englanti pokkari
The word pharmaceutics is used in pharmacy and pharmaceutical sciences to encompass many areas related to formulation of the medicines. Medicines are rarely with single ingredie...

Preeti Pundir; Krishnamurthy S L; Parbodh Chander Sharma · ISBN 9786202555692
Julkaistu 2020 Kieli englanti pokkari
Rice is the basic alimentary food for quite half of the human population all over the world and the most consumed cereal grain. After maize and wheat, it is the third largest cr...
Preeti Pundir; Menaka Salam; Parveen Kumar · ISBN 9786202563291
Julkaistu 2020 Kieli englanti pokkari
The use of cellulosic materials for second generation ethanol production would give several advantages such as minimizing the conflict between land use for food and fuel product...

Preeti K. Sharma; Shashi Sharma Sudhan; Amar Prakash Garg · ISBN 9786202681773
Julkaistu 2022 Kieli englanti pokkari

Preeti Singh; Atul Jadhav; Neetu Rani · ISBN 9786202803250
Julkaistu 2020 Kieli englanti pokkari
Every tooth and restorative material have their own stress pattern recognizing them in vital to prior to designing a restoration without failure potential. Building a restoratio...

Preeti Singh; Atul Jadhav; Neetu · ISBN 9786202854986
Julkaistu 2020 Kieli saksa nidottu
Jeder Zahn und jedes Restaurationsmaterial hat sein eigenes Spannungsmuster, das sie als wichtig erkennt, bevor eine Restauration ohne Versagenspotenzial entworfen wird. Der Auf...